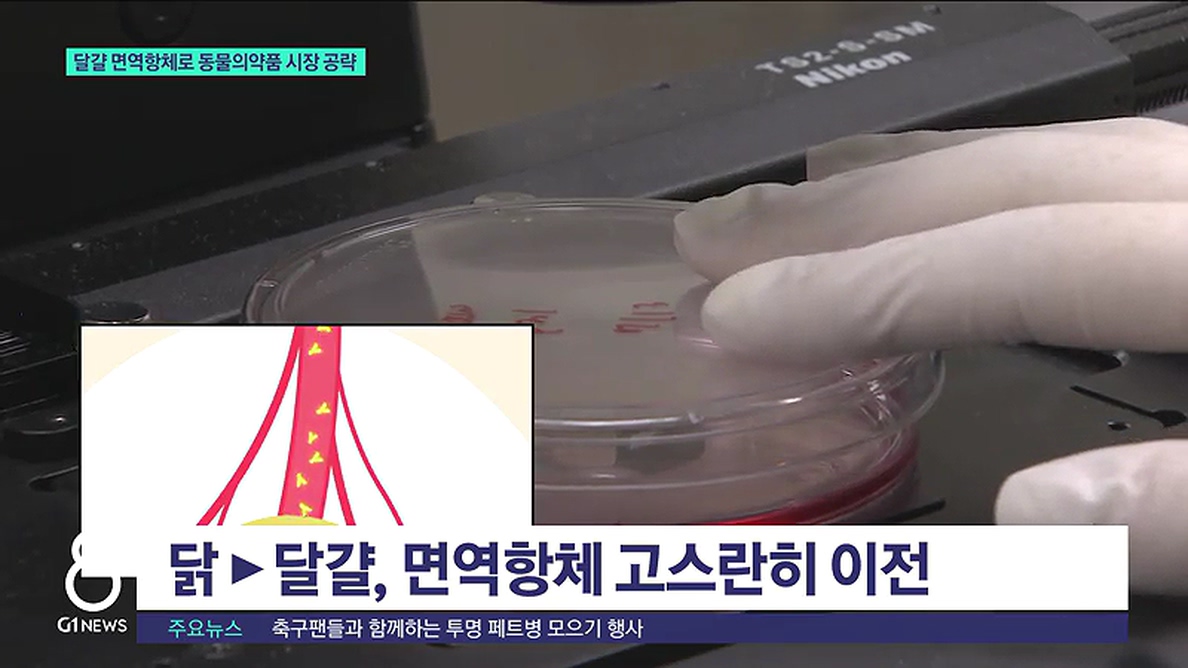

기획시리즈
<기획.2> 달걀 면역항체로 동물의약품 시장 공략
2021-07-18
원석진 기자[ won@g1tv.co.kr ]
키보드 단축키 안내
[앵커]
강원경제를 선도할 혁신기업을 소개하는 기획보도 순서입니다.
이번에 소개할 기업은 달걀 노른자로 항생제 대체 의약품을 제조하는 업체인데요.
강원지방중소벤처기업청이 선정한 혁신기업인 만큼, 성장가능성 역시 무궁무진합니다.
송아지와 새우, 사람에 이르는 맞춤형 항체 제품을 출시하면서 시장의 주목을 받고 있습니다.
원석진 기자가 보도합니다.
[리포터]
흰 가운을 입은 연구진들이 면역항체 개발에 몰두하고 있습니다.
언뜻 보기엔 제약회사 같지만, 이 기업은 좀 특별한 구석이 있습니다.
닭과 달걀의 유전 원리를 백분 활용하고 있기 때문입니다.
항원을 닭에게 주입하면 항체가 생기는데, 이 항체는 달걀 노른자에도 고스란히 옮겨집니다.
"이 발효기에선 닭에게 주입할 항원을 하루 만 배 가량 배양하고 있습니다."
달걀에서 난황항체 'IgY'를 추출하는데, 항생제의 부작용을 없앤 천연 약품입니다.
송아지 폐사의 주된 원인인 설사를 멈추기도 하고,
면역 체계가 없는 새우의 질병을 예방하는 역할도 합니다.
[인터뷰]
"실제로 현장에 나가서 각 농장이나 이런 데서, 닭이나 소나 돼지나, 이렇게 실험을 했었거든요. 거기서도 실험실 결과와 거의 유사한 좋은 효능을 보여서."
2000년 사료 첨가제 회사로 출발한 이 기업은, 4년 만에 의약품 회사로 과감하게 변신했습니다.
이제는 8천억 원대에 이르는 국내 IgY 시장을 선도할 뿐 아니라, 일본과 동남아 시장도 공략하고 있습니다.
세계 축산업을 쥐락펴락하고 있는 중국 시장에 진입하면, 면역항체 역시 극적인 성장을 이룰 것으로 기대하고 있습니다.
[인터뷰]
"무엇보다도 이제 중국 진출을 위해서 노력을 할 거고요. 글로벌 시장 공략을 위해서 제품 가격을 낮추고, 그런 방향으로 진행하려고 계획하고 있습니다."
면역항체의 새 역사를 쓰고 있는 이 기업은 상장절차를 밟기 위해 기업공개, IPO를 앞두고 있다고 밝혔습니다.
G1뉴스 원석진입니다.
강원경제를 선도할 혁신기업을 소개하는 기획보도 순서입니다.
이번에 소개할 기업은 달걀 노른자로 항생제 대체 의약품을 제조하는 업체인데요.
강원지방중소벤처기업청이 선정한 혁신기업인 만큼, 성장가능성 역시 무궁무진합니다.
송아지와 새우, 사람에 이르는 맞춤형 항체 제품을 출시하면서 시장의 주목을 받고 있습니다.
원석진 기자가 보도합니다.
[리포터]
흰 가운을 입은 연구진들이 면역항체 개발에 몰두하고 있습니다.
언뜻 보기엔 제약회사 같지만, 이 기업은 좀 특별한 구석이 있습니다.
닭과 달걀의 유전 원리를 백분 활용하고 있기 때문입니다.
항원을 닭에게 주입하면 항체가 생기는데, 이 항체는 달걀 노른자에도 고스란히 옮겨집니다.
"이 발효기에선 닭에게 주입할 항원을 하루 만 배 가량 배양하고 있습니다."
달걀에서 난황항체 'IgY'를 추출하는데, 항생제의 부작용을 없앤 천연 약품입니다.
송아지 폐사의 주된 원인인 설사를 멈추기도 하고,
면역 체계가 없는 새우의 질병을 예방하는 역할도 합니다.
[인터뷰]
"실제로 현장에 나가서 각 농장이나 이런 데서, 닭이나 소나 돼지나, 이렇게 실험을 했었거든요. 거기서도 실험실 결과와 거의 유사한 좋은 효능을 보여서."
2000년 사료 첨가제 회사로 출발한 이 기업은, 4년 만에 의약품 회사로 과감하게 변신했습니다.
이제는 8천억 원대에 이르는 국내 IgY 시장을 선도할 뿐 아니라, 일본과 동남아 시장도 공략하고 있습니다.
세계 축산업을 쥐락펴락하고 있는 중국 시장에 진입하면, 면역항체 역시 극적인 성장을 이룰 것으로 기대하고 있습니다.
[인터뷰]
"무엇보다도 이제 중국 진출을 위해서 노력을 할 거고요. 글로벌 시장 공략을 위해서 제품 가격을 낮추고, 그런 방향으로 진행하려고 계획하고 있습니다."
면역항체의 새 역사를 쓰고 있는 이 기업은 상장절차를 밟기 위해 기업공개, IPO를 앞두고 있다고 밝혔습니다.
G1뉴스 원석진입니다.
원석진 기자 won@g1tv.co.kr
Copyright ⓒ G1방송. All rights reserved. 무단 전재 및 재배포 금지.